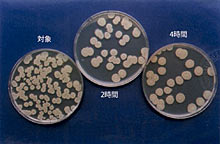

|


|

|

|
オゾン脱臭施工料金【8,000円〜】|東京都・神奈川県・千葉県・埼玉県
|

|

|

|
|



|
|

|


|
|

|




皆さんは、お友達の家やご近所の家に訪問されたときに、そのお家の臭いが気になりませんか?
当然、これからご入居をされるアパート・マンション・一戸建にも前に住んでいたご家庭の臭いがあります。
そんなときに「オゾン脱臭」(脱臭・消臭効果)で空気を綺麗にしてみませんか!
『オゾン』は自然界に存在する気体です。 オゾン層に代表されるように、地上にいる生物を紫外線や細菌などから守ってくれます。
このオゾンを人工的に発生させ、除菌や脱臭を行います。 その力は塩素の5倍以上です!しかも全く残留しません。
臭いは、元から断たなきゃダメ!ダメ!!
お住まいになっているご家庭の臭い(ペット、タバコ、カビ等)が気になる方
お子さんやご高齢者のためにお部屋の脱臭・殺菌をお考えの方
火災やボヤ後の建物内の焦げた匂いの脱臭
お線香や台所などの水廻りの臭いの消臭をお考えの方
ご不幸後の死臭の脱臭・消臭をお考えの方
にお勧めです♪
是非、ご利用ください!!オゾン脱臭で、いつもクリーンな空気を吸ってみませんか♪
【注意】 現在、お住まい(在宅)のお宅の場合、室内をオゾン脱臭されても衣類やカーテン、家財に付着した臭気が放散される事により再発することがございます。
 |
|
 |
| ボヤや火災後の脱臭にご検討ください。 |
|
ペットの匂いの脱臭にもご検討ください。 |


<オゾンとは>
オゾンは素晴らしい特性(殺菌・脱臭・鮮度保持・漂泊・ゴキブリ忌避)を有する物質であり、太古より自然界に存在する物質です。
20世紀、人類によって様々な化学物質が作り出され、同時にそれらによってもたらされる副作用や副生成物質の問題もクローズアップされました。
「21世紀の環境改善技術の切り札」といわれているオゾン。今まさにたくさんのお客さまにオゾンは認められつつあります。

<オゾンの性質>
オゾンは今から約160年前に発見された物質で、強力な酸化力を持っています。欧米では古くから上下水道の殺菌などに利用されてきました。わが国でも近年、その効力が認められ、身近な分野で利用されています。

オゾンの優れた特徴
○塩素の5倍以上、フッ素に次ぐ強力な酸化力を持つ
○空気中の酸素を原料に安価で容易に生成できる
○生成後は化学変化で自然に酸素に戻り、残留性がなく安全 |
|
|
 |



<オゾンによる脱臭効果>
オゾンによる脱臭は、悪臭を他の臭いで包み込み、ごまかしているだけの芳香剤とは違い、悪臭の素をオゾンが分解するため、より高い効果が得られます。

※下記の殺菌効果は、本サービスの主たる目的ではありません。 |
 |
 |

<オゾンによる殺菌効果>
一般に、薬剤による殺菌の場合、細菌やウイルスの細胞の核に作用し、殺菌します。これでは、その薬剤に対する耐性を持った菌やウイルスが発生する恐れがあります。一方オゾンによる殺菌は、細胞膜を破壊します。細胞膜が破壊されたことで細胞の核が溶け、菌が死滅しますので、耐性菌が発生する恐れはありません。さらに、オゾンは作用後、酸素へ戻るので安全です。 |
 |
 |
 |
 |



<殺菌効果>実験データ1:(財)日本食品分析センター調べ
試験内容
オゾン発生装置を設置したショーケース(約10℃)に細菌[セレウス菌、黄色ブドウ球菌及び腸炎ビブリオ]の菌液を塗抹した寒天平板培地(以下「試験平板」という)を入れ、オゾン(濃度0.1ppm)曝露させた。2及び4時間後試験平板を回収し、培養後生育した集落数を計測し生菌数とした。また、対照として、オゾン曝露せずにショーケースに試験平板を入れ、同様に試験した(4時間のみ)。なお、培養及び生菌数の測定は財団法人日本食品分析センター大阪支所にて行った。

| 試験結果 |
試験平板1枚あたりの生菌数 (財)日本食品分析センター調べ |
|
試験菌
|
オゾン曝露なし(4時間) |
オゾン曝露あり(2時間)
|
オゾン曝露あり(4時間) |
|
セレウス菌
|
200 |
37 |
36 |
|
黄色ブドウ球菌
|
390 |
3 |
2 |
|
腸炎ビブリオ菌
|
380 |
0 |
0 |
|

培養平板(セレウス菌)
|
 |
培養平板(黄色ブドウ球菌)
 |
 |
培養平板(腸炎ビブリオ菌)
 |

<オゾンによる殺菌効果試験>実験データ2:岡山県工業技術センター調べ
| ○試験菌名 |
黄色ブドウ球菌 |
| ○試験条件 |
管理温度 25℃
オゾン濃度 0.1ppm |
黄色ブドウ球菌に対してのオゾンガスによる殺菌効果は、25℃環境下においても顕著に現れている。
経過時間5時間及び6時間のサンプルの菌生存率が上昇しているが、2項オゾン曝露時間系列を見てもわかる様に、オゾン曝露を行うまでに4時間及び5時間程度25℃の環境下で保存されている為、その間に初期増殖が行われていると推測される。 |
 |
|

| ○試験菌名 |
セレウス菌 |
| ○試験条件 |
管理温度 25℃
オゾン濃度 0.1ppm |
セレウス菌に対してのオゾンガスによる殺菌効果は、25℃環境下においても充分な効果が見受けられる。 |
 |
|



■ハウスクリーニングコース(水周り集中・ひと安心・完璧)と同時施工の場合、下記の料金の40%引きとなります
| 間取り |
アパート・マンション |
一戸建住宅 |
| 1K |
25,000(税込27,000円) |
-- |
| 1DK |
30,000(税込32,400円)
|
-- |
| 1LDK・2DK |
40,000(税込43,200円) |
50,000(税込54,000円) |
| 2LDK・3DK |
60,000(税込44,800円)
|
75,000(税込81,000円) |
| 3LDK・4DK |
90,000(税込97,200円)
|
110,000(税込118,800円) |
| 4LDK・5DK |
135,000(税込145,800円)
|
165,000(税込178,200円) |
| 5LDK・6DK |
200,000(税込216,000円)
|
245,000(税込264,600円) |
| 6LDK・7DK |
275,000(税込297,000円)
|
320,000(税込345,600円) |
|

※火災後の脱臭は、必要に応じてスス汚れなどのケレン作業(別途お見積り)をお勧めすることがございます。
※お客様のご希望により部分リフォーム工事(クロス張替・キッチンセット取替、スケルトン工事、内装リノベーション)をおこないます。その場合、当社提携委の一級建築士がご相談に応じます。
※オフィス・店舗等は、別途お見積をさせていただきます。






営業エリア:東京都・神奈川県・千葉県・埼玉県
本社:〒252-0303 神奈川県相模原市南区相模大野5-6-7 TEL:042-701-1661(代) FAX:042-701-1671 フリーダイヤル0120-056-100
| 川崎営業所 |
〒214-0004 神奈川県川崎市多摩区菅馬場3-1-7サクセスビル 1F |
TEL:044-272-9119(代) FAX:044-272-9118 |
| 横浜営業所 |
〒225-0001 神奈川県横浜市青葉区美しが丘西1-22-7 |
TEL:045-901-9422(代) FAX:045-905-2322 |
営業時間:月〜土 9:00〜18:00(日祝はE-mailのみの受付となります / 年末年始を除く不定休)
許認可登録:建築物清掃業 川崎市30清第3号、請負賠償責任保険加入済
一級ビルクリーニング技能士・ハウスクリーニング技士・東京都職業訓練指導員・第三種電気主任技術者・劇毒物取扱責任者・消防設備士・
清掃作業監督者・貯水槽清掃作業者・防除作業従事者など有資格者在職

Copyright © 1999-2019 JOYTECH Co., Ltd. All Rights Reserved.
|
|

|